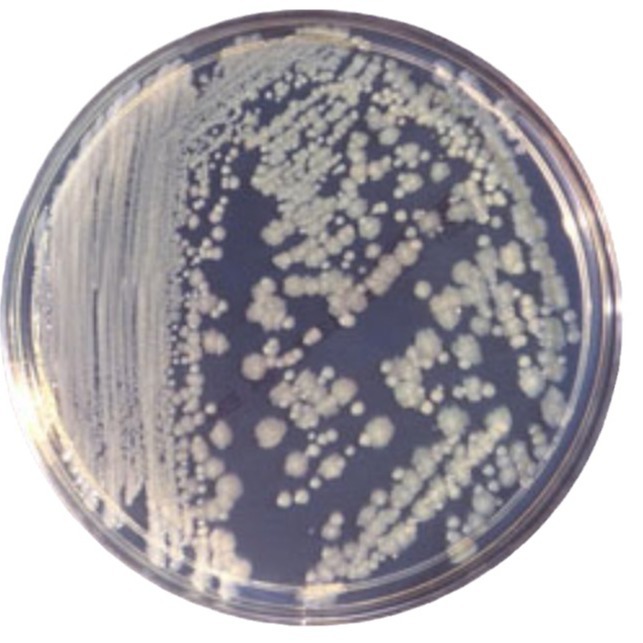

LB-2113 планктонный пробоотборник воздушной пыли может работать непрерывно в течение 7 часов
Всего продаж:
125 шт.
Минимальное количество для заказа:
1 шт.
LB-2113 планктонный пробоотборник воздушной пыли может работать непрерывно в течение 7 часов
от 40 000.00 ₽ за 1 шт.
-21%
40 000.00 ₽
Доставка по Китаю включена в цену
Оптом
от 1 шт.
40 000.00 ₽
Описание





Характеристики
Происхождение:
Циндао
Импорт или нет:
Нет
Номер заказа:
176 6090 6508
Размер:
22×14×2
Номер артикла:
Плавающая воздушная пыль пробоотборник
Обработка на заказ:
Нет
Точность обнаружения:
0.01
Тип:
Отбор проб пыли
Бренд:
Лубо
Сфера применения:
Смотрите описание для деталей
Модель:
LB-2113
Вес:
1.6
Является ли трансграничный экспорт выделенных источников поставок:
Нет
О продавце
Имя:
Оценка сервиса:
4.5
Оценка логистики:
3.2
Оценка споров и жалоб:
5.0
Оценка предложения:
3.6
Оценка консультации:
5.0
repeatPurchasePercent:
0.0
afterSalesExperienceScore:
3.6

LB-2113 планктонный пробоотборник воздушной пыли может работать непрерывно в течение 7 часов
40 000.00 ₽
40 000.00 ₽




 Курс юаня: 12.5
Курс юаня: 12.5